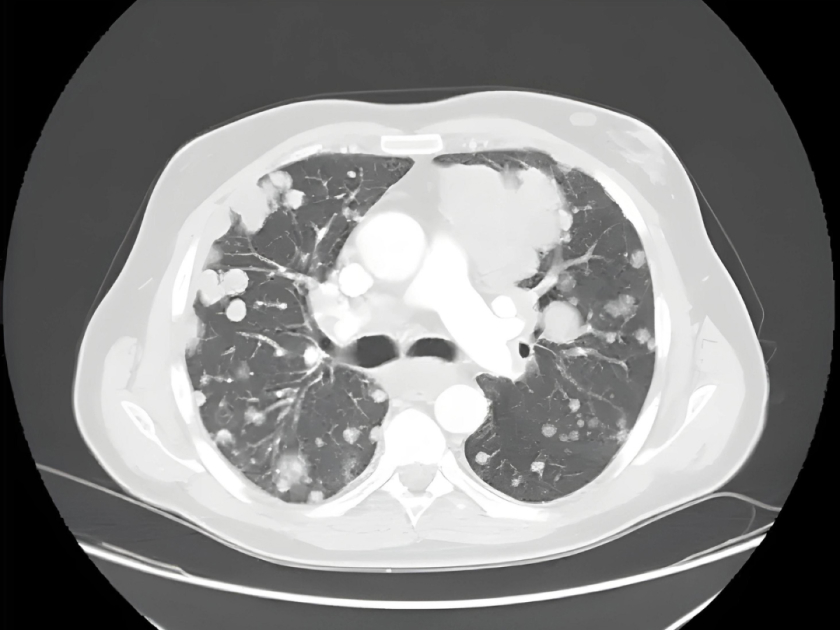
Metástasis pulmonares

El cáncer de pulmón es un cáncer que se forma en los tejidos del pulmón, generalmente en las células que recubren las vías respiratorias. Es la principal causa de muerte por cáncer tanto en hombres como en mujeres.
Leer más
El rubor facial es una reacción fisiológica natural y cotidiana que cualquier persona puede experimentar en cualquier situación de su vida y que se desencadena por situaciones que activan nuestro sistema de alerta o se producen en respuesta a estímulos físicos o psicológicos.
Leer más
La hiperhidrosis provoca sudoración excesiva sin relación con el calor o el ejercicio y puede afectar manos, axilas, rostro y pies. Esta condición impacta la vida diaria; sin embargo, hoy existe una solución definitiva mediante la cirugía de simpatectomía, un tratamiento seguro que mejora de forma permanente la calidad de vida.
Leer más
Las enfermedades pulmonares son algunas de las afecciones médicas más comunes del mundo. Decenas de millones de personas padecen enfermedades pulmonares solo en los EE.
Leer más
Las metástasis pulmonares son tumores cancerosos que comienzan en otra parte del cuerpo y se diseminan a los pulmones.
Leer más
La cirugía toracoscópica asistida por video (VATS) es una técnica quirúrgica mínimamente invasiva que se usa para diagnosticar y tratar problemas en el pecho. El toracoscopio transmite imágenes del interior de su pecho a un monitor de video, lo que guía al cirujano en la realización del procedimiento.
Leer más
El neumotórax generalmente se diagnostica mediante una radiografía de tórax. En algunos casos, podría ser necesaria una exploración por tomografía computarizada para brindar imágenes más detalladas.
Leer más
Un nódulo pulmonar es una pequeña área anormal que a veces se encuentra durante una tomografía computarizada del tórax. Estas exploraciones se realizan por muchas razones, como parte de la detección del cáncer de pulmón o para examinar los pulmones si tiene síntomas.
Leer más
La cavidad torácica (torácica o pleural) es un espacio que está encerrado por la columna vertebral, las costillas y el esternón y está separado del abdomen por el diafragma.
Leer más
La enfermedad quística hidatídica es una enfermedad importante en regiones endémicas. El quiste hidatídico pulmonar gigante es una enfermedad parasitaria causada por Echinococcus granulosus y se caracteriza por lesiones quísticas de 10 cm o más de diámetro en los pulmones.
Leer más
El trauma torácico causa aproximadamente el 25% de las muertes por traumatismo en los EE. UU. Muchas lesiones torácicas provocan la muerte durante los primeros minutos u horas posteriores al traumatismo.
Leer más
Los tumores mediastinales son masas o neoplasias que se forman en la mitad del área torácica, la cual separa los pulmones.
Leer más
Los tumores mediastinales son masas o neoplasias que se forman en la mitad del área torácica, la cual separa los pulmones.
Leer más
Es posible que se le considere para un trasplante de pulmón si le han diagnosticado una enfermedad pulmonar en etapa terminal y necesita un tratamiento que le salve la vida.
Leer más
La estenosis subglótica y traqueal son dos términos diferentes que se utilizan para describir un estrechamiento en las vías respiratorias.
Leer más












